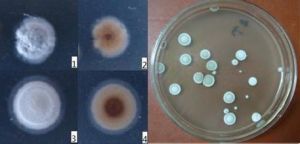
吸水鏈黴菌印度變種

基本信息
中文學名吸水鏈黴菌印度變種
拉丁學名Streptomyceshygroscopicusvar.indica
參考文獻Hind.Antibiot.Bull.7:25-29,1964.
吸水鏈黴菌印度變種
吸水鏈黴菌印度變種形態特徵孢子絲螺鏇形,時常緊密。
簡介
蔗糖硝酸鹽瓊脂:氣絲貧乏。基絲透明。葡糖天冬素瓊脂:氣絲灰麂色。基絲白色至淡肉桂黃色。在大部分培養基內無可溶色素。澱粉瓊脂平板:氣絲肉白色轉淡灰色。基絲好,白色。合成瓊脂:氣絲白色,有許多孢子,基絲白色。蘋果酸鈣瓊脂:氣絲微白色帶灰色斑。基絲微灰色。營養瓊脂:氣絲白色。基絲堊白色。葡萄糖瓊脂:氣絲白色轉藍灰色。基絲好,肉桂黃色。伊氏瓊脂:氣絲白色,有許多灰色斑。基絲好,肉桂褐色。酪氨酸瓊脂:氣絲堊白色,皮狀。基絲好,肉桂色。馬鈴薯塊:基絲少,淡黃色。薯塊不變色。明膠液化。牛奶腖化。澱粉水解弱。纖維素上生長。硝酸鹽還原可疑。不產生類黑色素、 酪氨酸酶和H2S。利用葡萄糖、阿拉伯糖、果糖、鼠李糖、甘露醇以及半乳糖、乳糖、甘露糖,麥芽糖、澱粉、菊糖、衛矛醇、水楊苷、檸檬酸鈉、琥珀酸鈉;不利用棉子糖以及七葉樹素、醋酸鈉。產生抗原蟲菌素(antlprotozoin),抑制真菌和原蟲。
盤點世界上的微生物(九)
| 微生物是包括細菌、病毒、真菌以及一些小型的原生動物、顯微藻類等在內的一大類生物群體,它個體微小,卻與人類生活關係密切。涵蓋了有益有害的眾多種類,廣泛涉及健康、食品、醫藥、工農業、環保等諸多領域。 |
